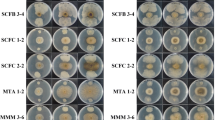

Abstract
Citrus fruits are the most produced fruits in the world, but they are threatened by several pathogens, including the fungus Phyllosticta citricarpa, the causal agent of citrus black spot (CBS). The fungus affects most citrus species and the infection results in economic losses in citrus-producing areas. This disease causes the aesthetic depreciation of fresh fruit, impairing its commercialization. As an alternative to the use of synthetic fungicides to control the pathogen, the biological control, using bacteria of the genus Bacillus, is highlighted. Such microorganisms enable biocontrol by the production of volatile organic compounds (VOC) or non-volatile. Therefore, this work aimed to evaluate the production of VOC by isolates of Bacillus spp. grown in different culture media; to evaluate the effects of these compounds on the evolution of CBS lesions in orange fruits; to study the effects of VOC on resistance induction in orange fruits; to evaluate the effects of VOC on P. citricarpa morphology in CBS lesions, and to identify the produced VOC. Tryptone soya agar (TSA) and tryptone soya broth (TSB) media used to culture the bacterium resulted in up to 73% pathogen inhibition by VOC. Volatile compounds from Bacillus spp. ACB-65 and Bacillus spp. ACB-73 when cultured in TSB culture medium provided 86% inhibition of freckles that evolved to hard spots. The volatile fractions produced by the bacteria were identified as alcohols, ketones, amines, ethers, aldehydes and carboxylic acids that can serve as arsenal against the phytopathogen. The present work demonstrated the potential of VOC produced by Bacillus spp. in the control of P. citricarpa.
Similar content being viewed by others
Avoid common mistakes on your manuscript.
Introduction
The citrus sector is the largest producer of fruits in the world and is mainly dedicated to the extraction of juices; but, a considerable proportion is supplied for direct consumption as fresh fruit (Palou et al. 2015). However, the citrus fruits are susceptible to different postharvest diseases that can affect the sector’s productivity. Among these, the citrus black spot (CBS), caused by Phyllosticta citricarpa (McAlpine) Petrak (teleomorph: Guignardia citricarpa Kiely).
The fruit symptoms of CBS can be very grave and lead to premature fruit drop in orchards where the disease is not satisfactory controlled and, the climate is favorable for the development of the disease (Lanza et al. 2018). The fungus P. citricarpa affects most citrus species and the infection results in severe economic losses in citrus-producing areas in Africa, Asia, Australia and South America. This disease affects the commercialization of the fresh fruits by causing their aesthetic depreciation in addition to issues resulting from phytosanitary barriers that are imposed by countries in the European community, where the pathogen is absent (Paul et al. 2005; Graham et al. 2014).
The use of synthetic fungicides, despite their limited efficiency, is the main method of disease control; however, the concern of consumers regarding chemical residues and the development of resistant pathogens has stimulated studies concerning new alternatives for disease control that are safer, more ecological, and sustainable (Feliziani and Romanazzi 2013; Bautista-Baños 2014; Mari et al. 2014).
In this context, biological control using Bacillus species is highlighted, due to its antagonistic activity in relation to several pathogens that cause losses in agriculture. In addition to acting in disease suppression, these species provide the possibility of reducing the use of agricultural inputs, with economic and environmental advantages. According to Giassi et al. (2016), Bacillus spp. isolates were able to promote growth of Swingle citrumelo, Sunki mandarin and Rangpur lime rootstocks in citrus and, Poveda and Gonzáles-Andrés (2021) related the production of phytohormones by Bacillus species highlighting their role in host plants and the mechanisms by which they are capable of increasing plant growth. Cui et al. (2019) demonstrated the effectiveness of B. amyloliquefaciens in the growth of maize seedlings, improving several enzymes associated with soil quality, increased chlorophyll content and antagonism against several important phytopathogens.
Bacillus spp. have the capacity to form endospores that guarantee their long maintenance and survival in different environments besides presenting a multiplicity of mechanisms of action that can act synergistically against phytopathogens (Fujimoto and Kupper 2016). These microorganisms allow biocontrol by the production of volatile organic compounds (VOC) or non-volatiles (Asari et al. 2016), which have antagonistic potential to several phytopathogens of various cultures in the pre- and post-harvest (Kim et al. 2010; Ashwini and Srividya 2014; Alamri 2015; Yamamoto et al. 2015; Zohora et al. 2016). Despite the recognized potential of Bacillus in the biological control of citrus phytopathogens (Kupper et al. 2012, 2019, 2016; Klein et al. 2013), little is known about the use of its volatile organic compounds in plant diseases control, as well as the chemical composition of the Bacillus VOC.
The use of VOC produced by microorganisms or fumigation with artificial volatile mixtures in post-harvest treatment of fruits can eliminate or inhibit pathogens during transport and storage, as well as minimize fruit manipulation, and can thus be a viable alternative as a non-residual control (Donahaye 2000). There are few fumigants available to control pathogens, sulfur dioxide is one of them, but it is not effective against preexisting infections (Adaskaveg et al. 2002). Currently, the ecological functions of VOC produced by microorganisms are not fully understood. According to Poveda (2021), the functions are related to increased plant growth, activation of plant defense responses and antibiosis against phytopathogens.
Many authors have reported promisingly the in vitro use of VOC produced by Bacillus against pathogens such as Penicillium digitatum, Rhizoctonia solani, Botrytis cinerea, Aspergillus spp. and others (Leelasuphakul et al. 2008; Solanki et al. 2015; Chaves-López et al. 2015), but there are few studies of their effects on post-harvest fruits.
Gotor-Vila et al. (2017) demonstrated the use of B. amyloliquefaciens VOC in the control of Monilinia laxa, Monilinia fructicola and B. cinerea in post-harvest sweet cherry fruits, reducing the incidence of diseases and sporulation of pathogens. Other studies can be found using yeast VOC in post-harvest disease control (Arrarte et al. 2017; Parafati et al. 2017). Toffano et al. (2017) reported the efficiency in the control of the citrus black spot in the post-harvest, when they performed the biofumigation of the fruits with VOC produced by Saccharomyces cerevisae, controlling up to 90% the development of new lesions of the disease.
Until now, there are no studies on the effect of Bacillus VOC on CBS control in post-harvest fruits. Considering this, the objectives of this work were: (i) to evaluate the production of volatile organic compounds by 27 isolates of Bacillus spp. grown in different culture media; (ii) to evaluate the effects of these compounds on the evolution of CBS lesions in orange fruits in the post-harvest period; (iii) to study the effects of VOC on resistance induction in orange fruits; (iv) to evaluate the effects of VOC on P. citricarpa morphology in CBS lesions, and (v) to identify the produced VOC.
Material and methods
Microorganisms
The Bacillus spp. isolates were obtained from samples of leaves and flowers of citrus trees collected in commercial citrus orchards in the State of São Paulo, Brazil (Kupper and Gimenes-Fernandes 2002). The 27 isolates of Bacillus spp. (ACB-15, ACB-16, ACB-18, ACB-19, ACB-20, ACB-22, ACB-24, ACB-41, ACB-46, ACB-47, ACB-52, ACB-54, ACB-56, ACB-58, ACB-59, ACB-60, ACB-63, ACB-64, ACB-65, ACB-66, ACB-67, ACB-68, ACB-69, ACB-70, ACB-71, ACB-73 and ACB-81) and the fungus P. citricarpa that were used in this study belongs to the collection of microorganisms from the “Laboratório de Fitopatologia e Controle Biológico” of the Centro APTA Citros Sylvio Moreira/IAC, Cordeirópolis/SP, Brazil. The choice of the Bacillus spp. isolates was based on previously obtained results (Fujimoto and Kupper 2016).
Effect of the culture media composition on the production of volatile organic compounds by Bacillus spp.
In this study, different media were tested for the cultivation of 27 isolates of Bacillus spp. aiming the increase of active volatile organic compounds (VOC) production against P. citricarpa, previously reported by Fujimoto and Kupper (2016). The media used were: potato dextrose agar (PDA) (4 g/L potato extract, 20 g/L dextrose and 15 g/L agar), king B (20 g/L proteose peptone n.3, 1.5 g/L MgSO4.7H2O, 1.5 g/L K2HPO4, 15 g/L of agar and 10 mL of glycerin), nutrient agar (NA) (3 g/L meat extract, 5 g/L peptone and 15 g/L agar), tryptone soya agar (TSA) (15 g/L enzymatic casein hydrolysate, 15 g/L agar, 5 g/L soy peptone, and 5 g/L sodium chloride) and tryptone soy broth (TSB) (17 g/L enzymatic casein hydrolysate, 3 g/L soy peptone, 5 g/L sodium chloride, 2.5 g/L D-glucose, 2.5 g/L of potassium dihydrogen phosphate and 15 g/L of agar). The methodology used for VOC production was adapted from that of Lopes et al. (2015).
In this study, two assays were performed with four replicates each using bipartite Petri dishes. On one side of the plate, the above mentioned culture medium for the bacterium was placed, and on the other side, PDA medium for the cultivation of P. citricarpa. 5-mm disks containing the bacterium and/or the pathogen were transferred to the respective media after solidification, and the plates containing the cultures were sealed. The control treatment consisted of bipartite Petri dish containing the plant pathogen in the absence of the bacterium. The cultures were incubated in Chamber for Biochemical Oxygen Demand (BOD) at 26 °C with a 12-h photoperiod. The evaluation occurred when the pathogen reached the border of the Petri dish in the control treatment; the colony of the fungus was measured in two perpendicular directions.
Effect of volatile compounds produced by Bacillus spp. in the evolution of lesions of type freckle spot to hard spot in orange fruits
In this study, two assays were performed with three replicates each. The first assay (Assay 1) was meant to evaluate the 27 isolates of Bacillus spp. that produced volatile organic compounds with activity against P. citricarpa (Fujimoto and Kupper 2016). The second assay (Assay 2) used six bacterial isolates (ACB-46, ACB-60, ACB-65, ACB-69, ACB-71 and ACB-73) that were selected based on the results obtained in Assay 1 of this study; these bacteria were subjected to different types of culture and their abilities to produce volatiles and potentially control the pathogen were determined.
Hamlin orange fruits were harvested from an orange commercial orchard that was located in the municipality of Engenheiro Coelho, São Paulo, Brazil. After their collection, the fruits were selected to obtain a batch of medium size and uniform maturation stage; all selected fruits presented symptoms of citrus black spot. Initially, the fruits were washed with neutral detergent and running water, and the lesions of freckle stain were pre-marked with a definitive pen to evaluate their development for the hard spot after the treatments.
For the treatment of fruits, in Assay 1, the 27 isolates of Bacillus were plated on PDA media; for Assay 2, the six selected isolates were plated on PDA and other media, TSA (ACB-46, ACB-60 and ACB-69 isolates) and TSB (ACB-65, ACB-71 and ACB-73 isolates), considering previous experiments. Part of the dishes with the isolates were used in the experiment immediately after plating (0 h), and the other part was incubated in a Chamber for BOD at 26 °C with 12-h photoperiod for 24 h. Initially, the covers of the polystyrene plates (where each Bacillus spp. isolate was being grown) were drilled (7 holes per cap and 0.4 cm diameter for each hole) and then deposited in the bottom of a 3-L glass jar. Afterwards, the fruits infected with the pathogen were placed, totaling 30 lesions with symptoms of freckle spot per jar. Another plate (containing the same Bacillus isolate) was deposited on the bottom of the glass vial and it was fixed inside of lid to ensure that the volatiles produced were well distributed in the container. The jars were hermetically sealed and the same procedure was followed for all treatments. Plates containing only culture medium were used as controls. The containers were kept at room temperature and under ambient light. The fruits remained inside the pots for 7 days. After the fruits were removed from the containers, they were kept at room temperature and 85% relative humidity (adapted from Toffano et al. 2017) (Fig. 1). The evaluations were carried out every 7 days, totaling 21 days; the first evaluation occurred soon after the withdrawal of the fruits from the glass pots, and the other two occurred with the fruits out of the container (Assay 1). For Assay 2, four evaluations were performed: the first three were performed as described for Assay 1, and the fourth was performed 10 days after the third evaluation, totaling 31 days. The evaluations were carried out by determining the percentage of lesions with symptoms of freckle spot that evolved to display the symptom of hard spot after the submission of the fruits to the volatile compounds that were produced by the bacterial isolates.
Demonstration scheme of the installation of the experiment to evaluate the effect of volatile compounds from Bacillus spp. on the development of citrus black spot (CBS) lesions. A Orange fruits selected with symptoms of CBS (freckle stain lesions), B and C glass jars containing polystyrene plates drilled with Bacillus spp. isolate, D Fruits removed from the containers and it were kept at room temperature and 85% relative humidity
Phenolic compounds and enzymatic activities
Citrus fruit, obtained from the best treatments (ACB-60 + TSA, ACB-65 + TSB, ACB-71 + TSB, ACB-73 + TSB, ACB-46 + PDA) in the experiment that evaluated the effect of VOC produced by Bacillus spp. On the development of CBS lesions, were used to analyze the production of phenolic compounds and enzymatic activities, as well as the fruits of the control treatment. Peel samples of the tested fruits were desiccated from CBS lesions (approximately 0.5 cm). The material was macerated with liquid nitrogen and stored in a freezer at − 80 °C until the experiments were carried out.
Analysis of phenolic compounds
In the preparation of the crude extract for phenols analysis, plastic tubes containing 100 mg of the macerated material plus 5 mL of 80% (v/v) methanol were used. Subsequently, the tubes were placed in an ultrasonic bath for 20 min and centrifuged at 5000 g for 10 min. The reaction was carried out in dark flasks containing 0.3 mL of the supernatant; 0.7 mL of distilled water; 2.5 mL of 20% (v/v) Na2CO3 and 0.5 mL folin–ciocalteau. The blank consisted of 0.3 mL of 80% (v/v) methanol; 0.7 mL of distilled water; 2.5 mL of 20% (v/v) Na2CO3 solution and 0.5 mL of folin ciocalteau. The vials were kept under agitation and absorbance measured at 725 nm after 1 h. The readings were plotted on an analytical curve from a gallic acid solution at a concentration of 1 mg/mL. For the curve, 50 mg of gallic acid was used, completing a 50 mL volumetric flask with 80% (v/v) methanol, removing a 2.5 mL aliquot by completing a 25 mL volumetric flask with 80% (v/v) methanol. Aliquots of this solution (0.2, 0.4, 0.6, 0.8, 1 mL) were diluted with distilled water to make up to 1 mL and added with 0.5 mL folin and 2.5 mL of a 20% Na2CO3 solution (m/v). Thereafter, the reading was carried out at 725 nm. The results were expressed as mg of gallic acid / 100 g−1 of fresh mass. Each treatment consisted of three replicates.
Analysis of polyphenol oxidase (PPO) and peroxidase (PO)
For the analysis of Polyphenol Oxidase (EC 1.10.3.1) and Peroxidase (EC 1.11.1.7) activities, the crude extract was prepared in plastic tubes containing 500 mg of the macerated material and 5 mL of potassium phosphate buffer at pH 6.7. The samples were centrifuged at 10,000 g for 5 min at 4° C and stored on ice. The PPO reaction was performed in test tubes containing 0.3 mL of the supernatant and 1.85 mL of catechol. The blank in the sample contained distilled water instead of the catechol. The general blank showed 0.3 mL of potassium phosphate buffer pH 6.7 and 1.85 mL of catechol. The tubes were incubated at 30 °C in a water bath for 30 min. Subsequently, the tubes were transferred to an ice bath, where 0.8 mL of perchloric acid was added, to interrupt the reaction. After shaking, the tubes were allowed to stand for 10 min and absorbance read at 395 nm in a spectrophotometer. The specific activity of Polyphenol Oxidase was expressed in μmol of catechol consumed min-1 mg-1 of soluble proteins (Cano et al. 1997).
The PO reaction was assembled in test tubes containing 0.6 mL of the supernatant; 0.5 mL of a solution A (2.2 mL of 30% H2O2 in 10 mL of distilled water, and of this solution, taken 0.5 mL and supplemented with 50 mL of potassium phosphate buffer pH 6.7) and 0.5 ml of a solution B (81.5 mg of phenol in 40 ml of distilled water, 40.65 mg of aminoantipyrine dissolved in 10 ml of distilled water and 40 ml of the phenol solution was added). For the sample blank, 0.6 mL of the supernatant and 1 mL of distilled water were used. The general blank contained 0.5 mL of solution A; 0.5 mL of solution B and 0.6 mL of potassium phosphate buffer pH 6.7. The tubes were incubated in a water bath at 30° C for 30 min. Then, the tubes were transferred to an ice bath, where 2 mL of absolute ethyl alcohol was added. After shaking, the tubes were allowed to stand for 10 min and the absorbance readout was then performed in a spectrophotometer at 505 nm. The specific activity of Peroxidase was expressed in μmol of H2O2 consumed min-1. mg-1 of soluble proteins (Allain et al. 1974).
Analysis of Phenylalanine Ammonia Lyase (PAL)
In the preparation of enzyme crude extract for the analysis of Phenylalanine Ammonia Lyase (EC 4.3.1.24), 300 mg of the macerated material was added to 10 mL of 0.1 mol/L borate buffer in an ice bath. Subsequently, samples were centrifuged at 6000 g at 4 °C for 40 min and the supernatant was collected. The reaction was performed in test tubes containing 1 mL of the supernatant and 1 mL of 0.2 mol/L borate buffer. The blank of the samples was composed of 1 mL of the supernatant and 2 mL of 0.2 mol/L borate buffer. For general blank 1 mL of 0.1 mol/L borate buffer and 1 mL of 0.2 mol/L borate buffer were used. The tubes were placed in a water bath at 36 °C, adding after 5 min, 1 mL of Phenylalanine in each tube, except in the tubes with the blank of the samples. These were incubated in a water bath for 1 h at 36 °C. Subsequently, 0.1 mL of 6 mol/L HCl was added to the tubes in ice bath to quench the reaction. The tubes were shaken and the spectrophotometric readings of absorbance were performed at 290 nm, subtracting from reading each sample, the reading of their control. The specific activity of PAL was defined as nmol of trans-cinnamic acid per min−1 per mg of total protein (methodology adapted from Lisker et al. 1983).
Effect of volatile compounds of Bacillus spp. in the morphology of hyphae and conidia of P. citricarpa in post-harvest fruits
The objective of this experiment was to verify the effect of volatile compounds on the hyphae of the fungus P. citricarpa using scanning electron microscopy as a tool. Fruits from the best treatments obtained in the previous test (Assay 2) were used.
Samples of the fruit peel (4 mm) were removed from the CBS lesions and fixed at room temperature by immersion in glutaraldehyde (2.5%) in 0.075 M phosphate buffer at pH 7.0 for 24 h to preserve the structural and morphological characteristics. The samples were then immersed in 1% osmium tetroxide in 0.075 M phosphate buffer at pH 7.0 for 1 h. After these steps, the samples were subjected to a series of dehydrations using increasing concentrations of ethanol (20, 30, 50, 70 and 100%) for 20 min each and then dried in a critical-point dryer. The dried fabrics were mounted on aluminum tops and coated with gold–palladium using a BAL-TEC 050 spray coater, and electron micrographs were taken on a JEOL scanning electron microscope (JMS-T300), operating at 10 keV (methodology adapted from Capdeville et al. 2007).
Statistical analysis
A completely randomized design was used, where the data were submitted to analysis of variance (ANOVA) and the means comparison was done by the Scott-Knott test at 5% probability using the Software Assistat 7.7 (Silva and Azevedo 2016).
Identification of VOC produced by Bacillus spp. through one-dimensional gas chromatography with mass spectrometry detection (GC–MS)
Two isolates of Bacillus spp. (ACB-65 and ACB-73) were selected based on their good results from the previous experiments that examined the control of CBS in post-harvest fruits. Bacteria were cultured in a device assembled using Falcon® 50-mL tubes with caps and an aluminum ring with a central hole and a Teflon® septum that contained 25 mL of TSB medium plus agar. The medium was poured along the entire wall of the tubes for higher growth of the isolates and, consequently, higher production of volatile compounds. The devices were stored in a greenhouse for BOD at 27 °C and with a 12-h photoperiod for 7 days.
The extraction of the volatile fraction constituting the headspace of the samples, contained in the extraction device, was performed by applying solid-phase microextraction (SPME).
Inasmuch as the VOC produced by Bacillus spp. are well known and consist of different classes of compounds (hydrocarbons, alcohols, aldehydes, ketones and others) and are thus metabolites with variable polarity, the extraction was carried out using a fiber coated with DVB/CAR/PDMS polymer (Divinylbenzene/ Carboxen/ Polydimethylsiloxane) at a film thickness of 50/30 μm (Supelco, Bellefonte, PA, USA) that was conditioned at 250 °C for 1 h prior to use (Effmert et al. 2012; Hynes et al. 2007).
The vials of the samples were fixed in a thermostatic water bath and placed on a shaker. Samples were equilibrated at 27 °C for 30 min. A needle was inserted through the Teflon® septum into the extraction device, and the SPME fiber was exposed to headspace of the specimen flask for 1 h. Volatile organic compounds from 25 mL of semi-solid TSB medium were used as controls. After the extraction, the SPME fiber was directly inserted into the gas chromatography injection port.
The SPME fibers were desorbed at 250 °C for 5 min in the GC/QMS-QP2010 (Shimadzu, Tokyo, Japan) injection port equipped with an HP-5MS capillary column (26 m in length, 0.25 mm in diameter, 0.25 μm thick) of 5% phenyl-95% polydimethylsiloxane (Supelco, Bellefonte, PA, USA). Samples were run for 41 min, and the fibers were conditioned at 250 °C for 10 min before being reused. The drag gas used was hydrogen. The initial oven temperature was 40 °C, which was held for 3 min; the temperature was ramped upward at 5 °C/min to 180 °C and then at 10 °C/min to 250 °C, where it was maintained for 3 min. The transfer line and ion source temperatures were 260 and 200 °C, respectively. The ions were detected in the range of 45–400 m/z. GCMSolution commercial software version 5.3 was used to acquire and analyze the chromatograms obtained by GC/QMS. (Shimadzu, Tokyo, Japan). Mass spectra of the unknown compounds were compared to those in the NIST08, NIST08s and FFNSC13 libraries.
Results
Effect of the culture media composition on the production of volatile compounds by Bacillus spp.
In Assay 1 and Assay 2, where the effect of five culture media on the production of VOC from Bacillus spp. was evaluated, the TSA and TSB media showed the best performance. Such media provided the highest production of volatile metabolites with an inhibitory effect on the development of P. citricarpa colonies (Figs. 2, 3 and 4). In the Assay 1, the TSA medium favored the production of volatiles by the bacteria leading to 34 to 73% pathogen inhibition, whereas the TSB medium inhibited the colony by 24 to 65%. In the Assay 2, the VOC produced in the TSA and TSB media inhibited the phytopathogen colony from 32 to 63% and from 22 to 63%, respectively. When compared in the two tests, only ACB-19, ACB-41 and ACB-54 were not favored by TSA and TSB media in VOC production; rather, their VOC production was favored when they were grown on King B (ACB-19) and NA (ACB-24, ACB-41 and ACB-54) media. Although NA, PDA and King B media statistically favored the production of VOC by the bacteria, the inhibition values of their fungus colonies were lower than those of the TSA and TSB media, and in some cases, the VOC production favored the growth of the pathogen (Figs. 3 and 4).
Inhibition of the colony of Phyllosticta citricarpa when subjected to the action of volatile compounds produced by Bacillus spp. (ACB-15, ACB-16, ACB-18, ACB-19, ACB-20, ACB-22, ACB-24, ACB-41, ACB-46, ACB-47, ACB-52, ACB-54 and ACB-56) in different culture media (NA, TSA, TSB, PDA and King B). Assay 1
Inhibition of the colony of Phyllosticta citricarpa when subjected to the action of volatile compounds produced by Bacillus spp. (ACB-58, ACB-59, ACB-60, ACB-63, ACB-64, ACB-65, ACB-66, ACB-67, ACB-68, ACB-69, ACB-70, ACB-71, ACB-73 and ACB-81) in different culture media (NA, TSA, TSB, PDA and King B). Assay 2
Effect of volatile compounds produced by Bacillus spp. in the evolution of lesions of type freckle spot to hard spot in orange fruits
The effects of the volatile compounds produced by Bacillus spp. on the evolution of the symptoms from freckle spots to hard spots in orange fruits are shown in Figs. 5 and 6.
Effect of volatile compounds of 27 isolates of Bacillus spp. (ACB-15, ACB-16, ACB-18, ACB-19, ACB-20, ACB-22, ACB-24, ACB-41, ACB-46, ACB-47, ACB-52, ACB-54, ACB-56, ACB-58, ACB-59, ACB-60, ACB-63, ACB-64, ACB-65, ACB-66, ACB-67, ACB-68, ACB-69, ACB-70, ACB-71, ACB-73 and ACB-81) with 24 h and 0 h of cultivation in PDA media on the evolution of lesions from freckles to hard spots. Three evaluations were carried out during a total of 21 days
Inhibition of the evolution of symptoms from freckle spot to hard spot after the fruits were submitted to the volatile compounds produced by Bacillus spp. (ACB-46, ACB-60, ACB-65, ACB-69, ACB-71 and ACB-73). The bacterial isolates were cultured in PDA and TSA or TSB medium and used in the assay immediately after plating (0 h) or 24 h later
Throughout the evaluations, there was an increase in the percentage of freckles that developed into hard spots; however, the frequency of this evolution was higher in the untreated fruits, and all the isolates of Bacillus spp. that were tested were able to produce volatile compounds that had inhibited the evolution of spots at the end of the 21-day evaluation (Assay 1, Fig. 5) and at the end of the 31-day evaluation (Assay 2, Fig. 6). The best treatments in the first trial used the ACB-60 isolate (0 h), which showed a mean inhibition of evolution of 89.83% when considering the values of the three evaluations (7, 14 and 21 days); the second-best treatment used the ACB-65 isolate (24 h), which provided an average inhibition of the three evaluations of 71.25% (Fig. 5).
In the second assay, the effect of volatile compounds from six isolates of Bacillus spp. (ACB-46, ACB-60, ACB-65, ACB-69, ACB-71 and ACB-73) on the evolution of the freckle spots to CBS hard spots in post-harvest fruits was evaluated. All treatments were effective in inhibiting the evolution of the freckle spots to hard spots, with inhibition values from 57 to 86.5% (Fig. 6). The best results were obtained using ACB-65, which exhibited a mean inhibition of 86.51%, and ACB-73 isolates, with a mean inhibition of 86.48%, grown in TSB medium at 0 h of age (Fig. 6). The fruits from these treatments were later submitted to scanning electron microscopy.
Phenolic compounds and enzymatic activities
Tissue samples were obtained from fruits after treatment with volatile organic compounds of Bacillus spp. to evaluate the production of phenols and enzymes indicative of induction of resistance. The production of phenolic compounds showed no alteration in relation to the treatments sampled, when compared with the values presented by their controls. In general, the analyzes showed high activity of the PPO and PO enzymes, in the most treatments and their controls. The only treatment that presented a decrease in PPO activity when compared to its control was the ACB-73 + TSB treatment. With regard to the PAL enzyme, it was verified that there was no significant difference in its activity in any of the treatments and its controls (data not shown).
Effect of volatile compounds of Bacillus spp. in the morphology of hyphae and conidia of P. citricarpa in post-harvest fruits
Scanning electron microscopy showed that there were changes in the morphology of the P. citricarpa fungus in post-harvest fruits after their treatment with the volatiles produced by Bacillus spp. (Fig. 7).
Electron scanning micrographs of citrus black spot (CBS) lesions in orange fruits. A–D: control fruit (A CBS lesion, B Phyllosticta citricarpa hyphae that are uniformly tubular and intact, C tangled P. citricarpa spores, and D CBS lesion), E–H: fruit treated with volatile metabolites of the isolate Bacillus amyloliquefaciens ACB-65 (E MPC lesion, F flattened P. citricarpa hyphae, G deformed fungal spores, and H wrinkled spore of P. citricarpa), and I–L: fruit treated with volatile metabolites of the isolate Bacillus subtilis ACB-73 (I MPC lesion, J–L: deformed phytopathogenic hyphae)
The images that were obtained showed that CBS lesions in the control fruits were more prominent (Fig. 7A) and much deeper (Fig. 7D) than those found in treated fruits, and the hyphae of P. citricarpa were uniformly tubular and intact (Fig. 7B). In the fruits that were treated with the volatile metabolites of Bacillus spp. ACB-65 and ACB-73, the CBS lesions were more superficial (Fig. 7E and I), and the hyphae of the pathogen were deformed (Fig. 7F, J, K and L). It is important to mention that in the fruits treated with the volatiles produced by ACB-65, the spores of the fungus were deformed (Fig. 7G) and wrinkled (Fig. 7H).
Identification of VOC produced by Bacillus spp. through one-dimensional gas chromatography with mass spectrometry detection (GC–MS)
The volatile fraction of the Bacillus isolates (ACB-65 and ACB-73) was extracted using SPME and subsequently subjected to GC–MS to identify the volatile metabolites that were produced. According to the chromatograms that were generated (Fig. 8), a similar metabolic profile was observed among the isolates tested. Analyzing the mass spectra obtained from each peak, the presence of twelve alcohols, nine ketones, four amines, three ethers, two aldehydes and a carboxylic acid were observed (Table 1).
Chromatograms of total ions obtained by GC–MS from volatile organic compounds of (A) Bacillus amyloliquefaciens ACB-65 and (B) Bacillus subtilis ACB-73 were grown in TSB media. Extraction conditions: 1 h of extraction at 27 °C with DVB/CAR/PDMS fiber. Chromatographic conditions: HP-5MS column (26 m × 0.25 mm × 0.25 μm), H2 (1 mL/min), injector temperature 250 °C, temperature program 40 °C to 180 °C (5 °C/min); 180 °C to 250 °C (10 °C/min)
Discussion
Due to the damage caused by P. citricarpa to the world citriculture and the problems resulting from the use of synthetic fungicides, biological control is an alternative. In this context, Bacillus species are among the most used because they control phytopathogens using VOC and non-volatile antibiotics (Asari et al. 2016).
In this work, the production of VOC by 27 isolates of Bacillus spp. and their antagonistic activity against P. citricarpa fungus were evaluated. All bacterial isolates tested were able to control the development of the pathogen, in vitro and in vivo, at different levels of inhibition. The culture medium of the bacterium was important for the production of these compounds and for the antagonism between the species. This result corroborates with the obtained by Asari et al. (2016). The authors studied the multiple effects of VOCs produced by B. amyloliquefaciens in the plant growth promotion and in the control of plant pathogens and they observed that the use of different culture media caused differences in the effects of these compounds. In the present study, there was a greater control of the pathogen when TSA and TSB media were used for bacterial cultivation due to VOC production, with values of up to 73% inhibition of fungal colonies (Figs. 3 and 4). It is believed that the presence of tryptone and peptone in these media has been important for the production of these metabolites or even stimulated the production of different bioactive volatile compounds. Similar results were obtained by Liu et al. (2008) working with the VOC of a B. subtilis isolate obtained more than 75% inhibition of pathogens (Sclerotinia sclerotiorum, Botrytis cinerea, Cercospora kikuchii) when the bacterium was cultured in TSB medium. In the present study, it was found that the composition of the culture medium influences the metabolism of microorganisms, resulting in the differential production of metabolites as a function of the substratum (Ezra et al. 2004; Ezra and Strobel 2003).
In the in vivo test with citrus fruits that were symptomatic of black spot, the 27 bacterial isolates that were studied were able to produce VOC that inhibited the development of freckles for hard spots at the end of 21 days of evaluation, and among the best treatments were the ACB-60 that was used immediately after plating (0 h) and the ACB-65 after 24 h of PDA culture (Fig. 5). When evaluating the production of VOC by the bacteria in different culture media and their effect on the control of the pathogen in citrus fruits (Assay 2), it was verified that the best results (86%), in terms of inhibitions of freckles for hard spots, were obtained with ACB-65 and ACB-73 that were cultured in TSB culture medium and used immediately after plating (0 h) (Fig. 6). The lack of evolution of the freckle spots to hard spots presents an interesting control, considering the aesthetic depreciation of the fruits and the development of the disease. Di Francesco et al. (2015) studying VOC produced by Aureobasidium pullulans strains against post-harvest pathogens demonstrated that 96% of the lesions were reduced when the fruits were inoculated artificially with pathogenic conidia and then fumigated with VOC emitted by the antagonists.
Analyzes of enzymatic activities related to citrus defense were carried out in order to understand the mechanisms by which VOC of Bacillus spp. were able to inhibit the development of CBS lesions in post-harvest fruits. According to Xu et al. (2013), plants synthesize and accumulate proteins during processes of pathogenesis and induced resistance, which may be one of the mechanisms used by microorganisms in disease control. Phenolic compounds and enzymes such as PPO, PO and PAL, studied in the respective work, are compounds involved in plant resistance and can be induced for several reasons, such as phytopathogenic infection or application of a biocontrol agent (Lu et al. 2013). Shafi et al. (2017) related that Bacillus species produce many defense-related oxidative enzymes, such as PPO, PO and PAL and the defense-related activities of the enzymes have been cited in several plants against diverse plant pathogens (Thilagavathi et al. 2007). Nonetheless this study did not demonstrate an increase in the production of phenolic compounds and in the enzymatic activities of PPO, PO and PAL in fruits that were treated with the volatile metabolites of Bacillus spp. when compared to their controls. Most likely, VOC had a direct effect on the fungus P. citricarpa and the high enzymatic activities presented by the treatments, in general, may be due to infection of the pathogen in the field, before harvest. Contrary to the results obtained in this study, many authors attribute the control of plant diseases to the induction of resistance through the direct use of antagonistic microorganisms or their metabolites that can act as elicitors (Araujo and Menezes 2009; Chowdappa, et al. 2013; Silva et al. 2007; Xu et al. 2013).
In the fruits that were treated with the volatile metabolites of Bacillus spp. ACB-65 and ACB-73, the hyphae of P. citricarpa were flattened, twisted and deformed, in addition to apparently having a reduced amount of phytopathogen conidia at the lesion site. It is shown in the scanning electron microscope images that the bacterial isolate ACB-65 affected the spores of the fungus (Fig. 6). Similar results were found by Solanki et al. (2015), when studying the effects of isolates of B. subtilis and B. amyloliquefaciens on the fungus Rhizoctonia solani, they obtained up to 87% inhibition in phytopathogen development using VOC produced by bacteria. According to the authors, these compounds caused the deformation and death of the hyphae, facts confirmed by scanning electron microscopy. Other authors have also verified deformations in the hyphae and spores of phytopathogenic fungi (Macrophomina phaseolina) caused by volatile compounds from B. subtilis and B. amyloliquefaciens (Torres et al. 2016). Chaves-López et al. (2015) working with the same species of bacteria, found similar results against different phytopathogens.
GC–MS analysis of the volatile metabolites produced by Bacillus ACB-65 and ACB-73 demonstrated the presence of 32 compounds distributed among alcohols, ketones, amines, ethers, aldehydes and carboxylic acids that can serve as an arsenal of compounds in microbial antagonism. All identified compounds were previously reported to be produced by Bacillus species (Asari et al. 2016; Chaves-López et al. 2015; Liu et al. 2008). The compounds 2-ethyl-1-hexanol and 2-nonanol, also described in this work, were studied by Fernando et al. (2005), who have demonstrated that these compounds can completely inhibit the growth of Sclerotinia sclerotiorum. They also identified the compound 2-undecanone, but it did not present inhibitory activity. The linalool identified in the present study was reported by several authors, presenting its great antimicrobial potential. Queiroba et al. (2007), working with Bursera aloexylon oil, found that it contained a high level of linalool (96.7%), and it presented antimicrobial activity against Rhodococcus equi and Staphylococcus epidermidis. Similar results were obtained by Herman et al. (2016), who demonstrated the potential of the compound in the control of Pseudomonas aeruginosa, Aspergillus brasiliensis, Staphylococcus aureus, Escherichia coli and Candida albicans.
The 27 isolates of Bacillus that were studied in the present work probably produce different bioactive compounds that determine the different levels of observed antagonism. The use of these compounds in the control of diseases is very advantageous, and according to Wheatley (2002), the VOC are ideal infochemicals since they can act at great distances by diffusing through the air and in the pores of the ground soil; in that aspect, considering the epidemiology of citrus black spot, they could be used to prevent the formation of ascospores.
The present work demonstrated the potential of volatile organic compounds produced by Bacillus isolates to control P. citricarpa in vitro and in vivo. Various compounds may be related to the inhibition of the pathogen, as demonstrated in this work; however, some compounds may have no effect, have a negative effect, or act in consortium with other specific compounds to provide antagonism. As an alternative to the use of synthetic fungicides for CBS control, some of the volatiles produced by bacterial isolates, in particular, by ACB-65 and ACB-73, could be used for the development of new bioproducts, and more in-depth studies are needed.
References
Adaskaveg JE, Förster H, Sommer NF (2002) Principles of postharvest pathology and management of decays of edible horticultural crops. In: Kader A (ed) Postharvest technology of horticultural crops, 4th edn. UC DANR Publ 3311. Oakland CA 163–195
Alamri SA (2015) Enhancing the efficiency of the bioagent Bacillus subtilis JF419701 against soil-borne phytopathogens by increasing the productivity of fungal cell wall degrading enzymes. Archives of Phytopathol and Plant Prot 48:159–170
Allain CC, Poon LS, Chan CSG, Richmond W, Fu PC (1974) Enzymatic determination of total serum colesterol. Clin Chem 120:470–475
Araujo FF, Menezes D (2009) Indução de resistência a doenças foliares em tomateiro por indutores biótico (Bacillus subtilis) e abiótico (Acibenzolar-S-Metil). Summa Phytopathol 35:169–172
Arrarte E, Garmendia G, Rossini C, Wisniewski M, Vero S (2017) Volatile organic compounds produced by Antarctic strains of Candida sake play a role in the control of postharvest pathogens of apples. Biol Control 109:14–20
Asari S, Matzén S, Petersen MA, Bejai S, Meijer J (2016) Multiple effects of Bacillus amyloliquefaciens volatile compounds: plant growth promotion and growth inhibition of phytopathogens. FEMS Microbiol. Ecology 92:fiw070
Ashwini N, Srividya S (2014) Potentiality of Bacillus subtilis as biocontrol agent for management of anthracnose disease of chilli caused by Colletotrichum gloeosporioides OGC1. 3 Biotech 4:127–136
Bautista-Baños S (2014) Postharvest decay. Control Strategies. Elsevier, London, UK. Cano MP, Ancos B de, Matallana MC, Cámara M, Reglero G, Tabera J (1997) Differences among Spanish and Latin-American banana cultivars: morphological, chemical and sensory characteristics. Food Chem 59:411–419
Cano MP, Ancos B, Matallana MC, Cámara M, Reglero G, Tabera J (1997) Differences among Spanish and Latin-American banana cultivars: morphological, chemical and sensory characteristics. Food Chem 59:411–419
Capdeville GD, Souza Júnior MT, Santos JRP, Miranda SP, Caetano AR, Falcão R, Gomes ACMM (2007) Scanning electron microscopy of the interaction between Cryptococcus magnus and Colletotrichum gloeosporioides on papaya fruit. Pesq Agropec Bras 42:1537–1544
Chaves-López C, Serio A, Gianotti A, Sacchetti G, Ndagijimana M, Ciccarone C, Paparella A (2015) Diversity of food-borne Bacillus volatile compounds and influence on fungal growth. J Appl Microbiol 119:487–499
Chowdappa P, Kumar SM, Lakshmi MJ, Upreti KK (2013) Growth stimulation and induction of systemic resistance in tomato against early and late blight by Bacillus subtilis OTPB1 or Trichoderma harzianum OTPB3. Biol Control 65:109–117
Cui W, He P, Munir S, He P, Li X, Li Y, Wu J, Wu Y, Yang L, He Y (2019) Efficacy of plant growth promoting bacteria Bacillus amyloliquefaciens B9601–Y2 for biocontrol of southern corn leaf blight. Biol Control 139:104080
Di Francesco A, Ugolini L, Lazzeri L, Mari M (2015) Production of volatile organic compounds by Aureobasidium pullulans as a potential mechanism of action against postharvest fruit pathogens. Biol Control 81:8–14
Donahaye EJ (2000) Current status of non-residual control methods against stored product pests. Crop Prot 19:571–576
Effmert U, Kalderás J, Warnke R, Piechulla B (2012) Volatile mediated interactions between bacteria and fungi in the soil. J Chem Ecol 38:665–703
Ezra D, Strobel GA (2003) Effect of substrate on the bioactivity of volatile antimicrobials produced by Muscodor albus. Plant Sci 165:1229–1238
Ezra D, Hess WM, Strobel GA (2004) New endophytic isolates of Muscodor albus, a volatile-antibiotic-producing fungus. Microbiol 150:4023–4031
Feliziani E, Romanazzi G (2013) Preharvest application of synthetic fungicides and alternative treatments to control postharvest decay of fruit. Stewart Postharvest Rev 9:1–6
Fernando WD, Ramarathnam R, Krishnamoorthy AS, Savchuk SC (2005) Identification and use of potential bacterial organic antifungal volatiles in biocontrol. Soil Biol and Biochem 37:955–964
Fujimoto A, Kupper KC (2016) Production of Antifungal Compounds and Hydrolytic Enzymes by Bacillus spp. as Mechanisms of Action against Phyllosticta citricarpa. IOSR J Agric and Vet Sci 9:19–27
Giassi V, Kiritani C, Kupper KC (2016) Bacteria as growth-promoting agents for citrus rootstocks. Microbiol Res 190:46–54
Gotor-Vila A, Teixidó N, Di Francesco A, Usall J, Ugolini L, Torres R, Mari M (2017) Antifungal effect of volatile organic compounds produced by Bacillus amyloliquefaciens CPA-8 against fruit pathogen decays of cherry. Food Microbiol 64:219–225
Graham JH, Gottwald TR, Timmer LW, Bergamin Filho A, Van Den Bosch F, Irey MS, Takeuchi Y (2014) Response to “Potential distribution of citrus black spot in the United States based on climatic conditions.” Eur J Plant Pathol 139:231–234
Herman A, Tambor K, Herman A (2016) Linalool affects the antimicrobial efficacy of essential oils. Curr Microbiol 72:165–172
Hynes J, Müller CT, Jones TH, Boddy L (2007) Changes in volatile production during the course of fungal mycelial interactions between Hypholoma fasciculare and Resinicium bicolor. J Chem Ecol 33:43–57
Kim PI, Ryu J, Kim YH, Chi YT (2010) Production of biosurfactant lipopeptides Iturin A, fengycin and surfactin A from Bacillus subtilis CMB32 for control of Colletotrichum gloeosporioides. J Microbio and Biotechnol 20:138–145
Klein MN, Silva AC, Lopes MR, Kupper KC (2013) Application of microorganisms, alone or in combination, to control postbloom fruit drop in citrus. Trop Plant Pathol 38:505–512
Klein MN, Silva AC, Kupper KC (2016) Bacillus subtilis based-formulation for the control of postbloom fruit drop of citrus. World J Microbiol and Biotechnol 32:205
Kupper KC, Gimenes-Fernandes N (2002) Isolamento e seleção de Bacillus spp. para o controle de Colletotrichum acutatum em flores destacadas de lima ácida ´Tahiti´. Summa Phytopathol 28:292–295
Kupper KC, Correa FE, de Azevedo FA, Silva AC (2012) Bacillus subtilis to biological control of postbloom fruit drop caused by Colletotrichum acutatum under field conditions. Sci Hortic 134:139–143
Kupper KC, Moretto RK, Fujimoto A (2019) Production of antifungal compounds by Bacillus spp. isolates and its capacity for controlling citrus black spot under field conditions. World J Microbiol and Biotechnol 36:7
Lanza FE, Metzker TG, Vinhas T, Behlau F, Silva Junior GJ (2018) Critical fungicide spray period for citrus black spot control in São Paulo state, Brazil. Plant Dis 102:334–340
Leelasuphakul W, Hemmanee P, Chuenchitt S (2008) Growth inhibitory properties of Bacillus subtilis strains and their metabolites against the green mold pathogen (Penicillium digitatum Sacc.) of citrus fruit. Postharvest Biol and Technol 48:113–121
Lisker N, Cohen L, Chalutz E, Fuchs Y (1983) Fungal infections suppress ethylene-induced phenylalanine ammonia-lyase activity in grapefruit. Physiol Plant Pathol 22:331–338
Liu W, Mu W, Zhu B, Liu F (2008) Antifungal activities and components of VOCs produced by Bacillus subtilis G8. Cur Res in Bacteriol 1:28–34
Lopes MR, Klein MN, Ferraz LP, Silva AC, Kupper KC (2015) Saccharomyces cerevisiae: a novel and efficient biological control agent for Colletotrichum acutatum during pre-harvest. Microbiol Res 175:93–99
Lu L, Lu H, Wu C, Fang W, Yu C, Ye C, Shi Y, Yu T, Zheng X (2013) Rhodosporidium paludigenum induces resistance and defense-related responses against Penicillium digitatum in citrus fruit. Postharvest Biol and Technol 85:196–202
Mari M, Di Francesco A, Bertolini P (2014) Control of fruit postharvest diseases: old issues and innovative approaches. Stewart Postharvest Rev 10:1–4
Palou L, Valencia-Chamorro SA, Pérez-Gago MB (2015) Antifungal edible coatings for fresh citrus fruit: a review. Coatings 5:962–986
Parafati L, Vitale A, Restuccia C, Cirvilleri G (2017) Performance evaluation of volatile organic compounds by antagonistic yeasts immobilized on hydrogel spheres against gray, green and blue postharvest decays. Food Microbiol 63:191–198
Paul I, Van Jaarsveld AS, Korsten L, Hattingh V (2005) The potential global geographical distribution of Citrus Black Spot caused by Guignardia citricarpa Kiely: The likelihood of disease establishment in the European Union. Crop Prot 24:297–308
Poveda J (2021) Beneficial effects of microbial volatile organic compounds (MVOCs) in plants. Appl Soil Ecol 168:104118
Poveda J, González-Andrés F (2021) Bacillus as a source of phytohormones for use in agriculture. Appl Microbiol Biotecnol 105:8629–8645
Queiroga CL, Duarte MCT, Ribeiro BB, Magalhães PM (2007) Linalool production from the leaves of Bursera aloexylon and its antimicrobial activity. Fitoterapia 78:327–328
Shafi J, Tian H, Ji M (2017) Bacillus species as versatile weapons for plant pathogens: a review. Biotech & Biotech Equip 31:446–459
Silva FDAS, Azevedo CAV (2016) The Assistat Software Version 7.7 and its use in the analysis of experimental data. Afr J Agric Res 11:3733–3740
Silva RF, Pascholati SF, Bedendo IP (2007) Indução de resistência em tomateiro por extratos aquosos de Lentinula edodes e Agaricus blazei contra Ralstonia solanacearum. Fitopatol Bras 32:189–196
Solanki MK, Singh RK, Srivastava S, Kumar S, Kashyap PL, Srivastava AK (2015) Characterization of antagonistic-potential of two Bacillus strains and their biocontrol activity against Rhizoctonia solani in tomato. J Basic Microbiol 55:82–90
Thilagavathi R, Saravanakumar D, Ragupathi N, Samiyappan R (2007) A combination of biocontrol agents improves the management of dry root rot (Macrophomina phaseolina) in greengram. Phytopathol Mediterr 46:157–167
Toffano L, Fialho MB, Pascholati SF (2017) Potential of fumigation of orange fruits with volatile organic compounds produced by Saccharomyces cerevisiae to control citrus black spot disease at postharvest. Biol Control 108:77–82
Torres MJ, Brandan CP, Petroselli G, Erra-Balsells R, Audisio MC (2016) Antagonistic effects of Bacillus subtilis subsp. subtilis and B. amyloliquefaciens against Macrophomina phaseolina: SEM study of fungal changes and UV-MALDI-TOF MS analysis of their bioactive compounds. Microbiol Res 182:31–39
Wheatley RE (2002) The consequences of volatile organic compound mediated bacterial and fungal interactions. Ant Van Leeuwenhoek 81:357–364
Xu B, Zhang H, Chen K, Xu Q, Yao Y, Gao H (2013) Biocontrol of postharvest Rhizopus decay of peaches with Pichia caribbica. Cur Microbiol 67:255–261
Yamamoto S, Shiraishi S, Kawagoe Y, Mochizuki M, Suzuki S (2015) Impact of Bacillus amyloliquefaciens S13–3 on control of bacterial wilt and powdery mildew in tomato. Pest Man Sci 71:722–727
Zohora US, Ano T, Rahman MS (2016) Biocontrol of Rhizoctonia solani K1 by Iturin A Producer Bacillus subtilis RB14 Seed Treatment in Tomato Plants. Adv Microbiol 6:424
Acknowledgements
To the financial support of CAPES, which provided a scholarship to Andréia Fujimoto; to the Agricultural Microbiology Program of Universidade Estadual Paulista “Júlio de Mesquita Filho”, Jaboticabal/SP, Brazil, is gratefully acknowledged and the financial support of the INCT Citrus (Proc. CNPQ465440/2014–2 and FAPESP 2014/50880–0).
Author information
Authors and Affiliations
Corresponding author
Additional information
Publisher's Note
Springer Nature remains neutral with regard to jurisdictional claims in published maps and institutional affiliations.
Supplementary Information
Below is the link to the electronic supplementary material.
Rights and permissions
About this article
Cite this article
Fujimoto, A., Augusto, F., Fill, T.P. et al. Biocontrol of Phyllosticta citricarpa by Bacillus spp.: biological and chemical aspects of the microbial interaction. World J Microbiol Biotechnol 38, 53 (2022). https://doi.org/10.1007/s11274-021-03214-z
Received:
Accepted:
Published:
DOI: https://doi.org/10.1007/s11274-021-03214-z